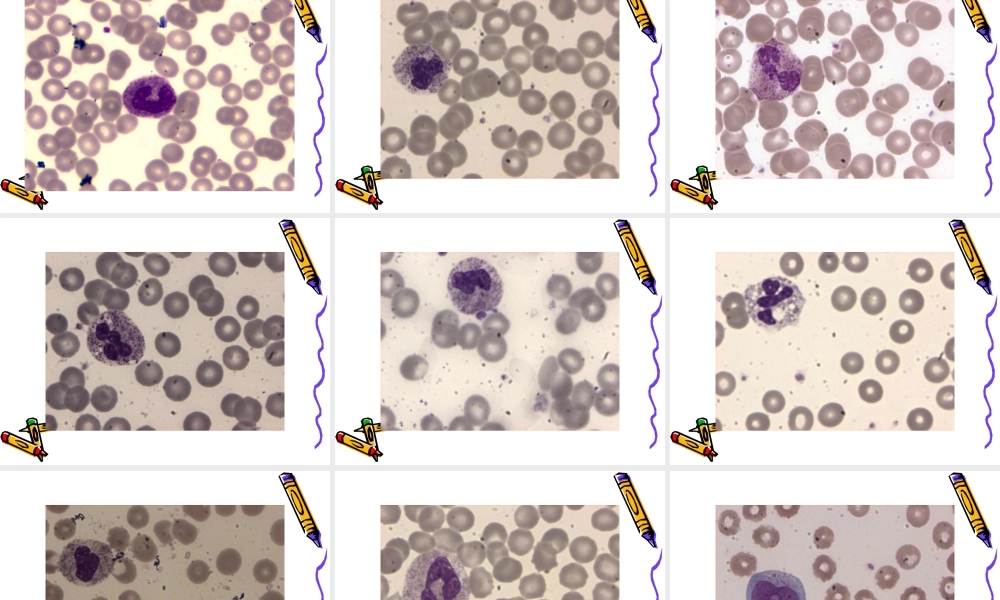
血细胞形态2014.ppt

外周血细胞形态学检查外周血细胞形态学检查外周血细胞形态学检查外周血细胞形态学检查赤峰学院附属医院检验科赤峰学院附属医院检验科张皓张皓血细胞分析是临床诊疗工作中常做的检验项目,血细胞分析仪广泛用于全血细胞计数,随着自动化血细胞分析仪的普及和仪器性能的提高,使检验结果更加准确,但是全自动血细胞分析仪也存在着内在缺陷,由于血细胞形态的多样化和复杂性,只能提供血细胞多少、大小、分布及相互间比例,得出正常或异常的提示,不能直接提供血细胞质量改变的确切信息,如过度依赖会出现漏诊和误诊。对于发热、贫血和血细胞异常的标本,在鉴别感染性疾病和非感染性疾病,病毒性感染和细菌性感染等必须做外周血的形态学检查。血液涂片制备取末梢血1滴,置于载玻片的一端,以边缘平滑的推片(推片两端应平整光滑,比载片稍窄或磨去两角)的一端,放在血滴前方,逐渐后移接触血滴,血液立即沿推片散开。然后将推片与载玻片保持30-45度角,平稳地向前推动至载玻片的另一端,载玻片上便留下一薄层血膜。血涂片制成后,立即在空气中挥动,迅速干燥,以免血细胞形态改变。血膜干燥后,用铅笔在厚血膜处写明病人姓名或编号。血液涂片制备是血液学检查重要的基本技术之一。一张良好的血片,厚薄要适宜,头体尾要明显,细胞分布要均匀,血膜边缘要整齐,并留有一定的空隙。试剂配制1、瑞氏染液将瑞氏染料0.1g粉放在清洁干燥的乳钵里,加少量甲醇,充分研磨使染料溶解。将巳溶解的染料倒入棕色试剂瓶中,未溶解的再加少量甲醇研磨,直至染料全部溶解,60毫升甲醇全部用完为止。或将瑞氏粉和甲醇直接置于棕色瓶中,加适量碎玻璃,立即振荡混合5分钟(一般600ml甲醇加瑞氏粉1.2~1.5g),置37℃水浴中3天,每天振摇混合2~3次,促其溶解,待一周后方可使用。新配染料的染色效果较差,放置愈久天青愈多,染色效果愈好。染液中也可加中性甘油3.0ml,防止甲醇挥发,使细胞染色较清晰。2、磷酸盐缓冲液(pH6.4~6.8)磷酸二氢钾(KH2P04)0.3g,磷酸氢二钠(Na2HP04)0.2g,蒸馏水加至1000.0ml。配好后用磷酸盐溶液校正pH,塞紧瓶口贮存。染色方法1、将制备好血涂片平放在染色架上。2、先加瑞氏染液数滴,覆盖整个血膜,固定细胞0.5~1min。3、按1:1或1:2加磷酸盐缓冲液,与染料混匀,染色10min左右。4、用接近中性的水冲去染液,待自然干燥或用滤纸吸干后,用油镜观察。5、染色结果在正常情况下,血膜外观为淡紫红色。在显微镜下红细胞染粉红色,在厚薄...